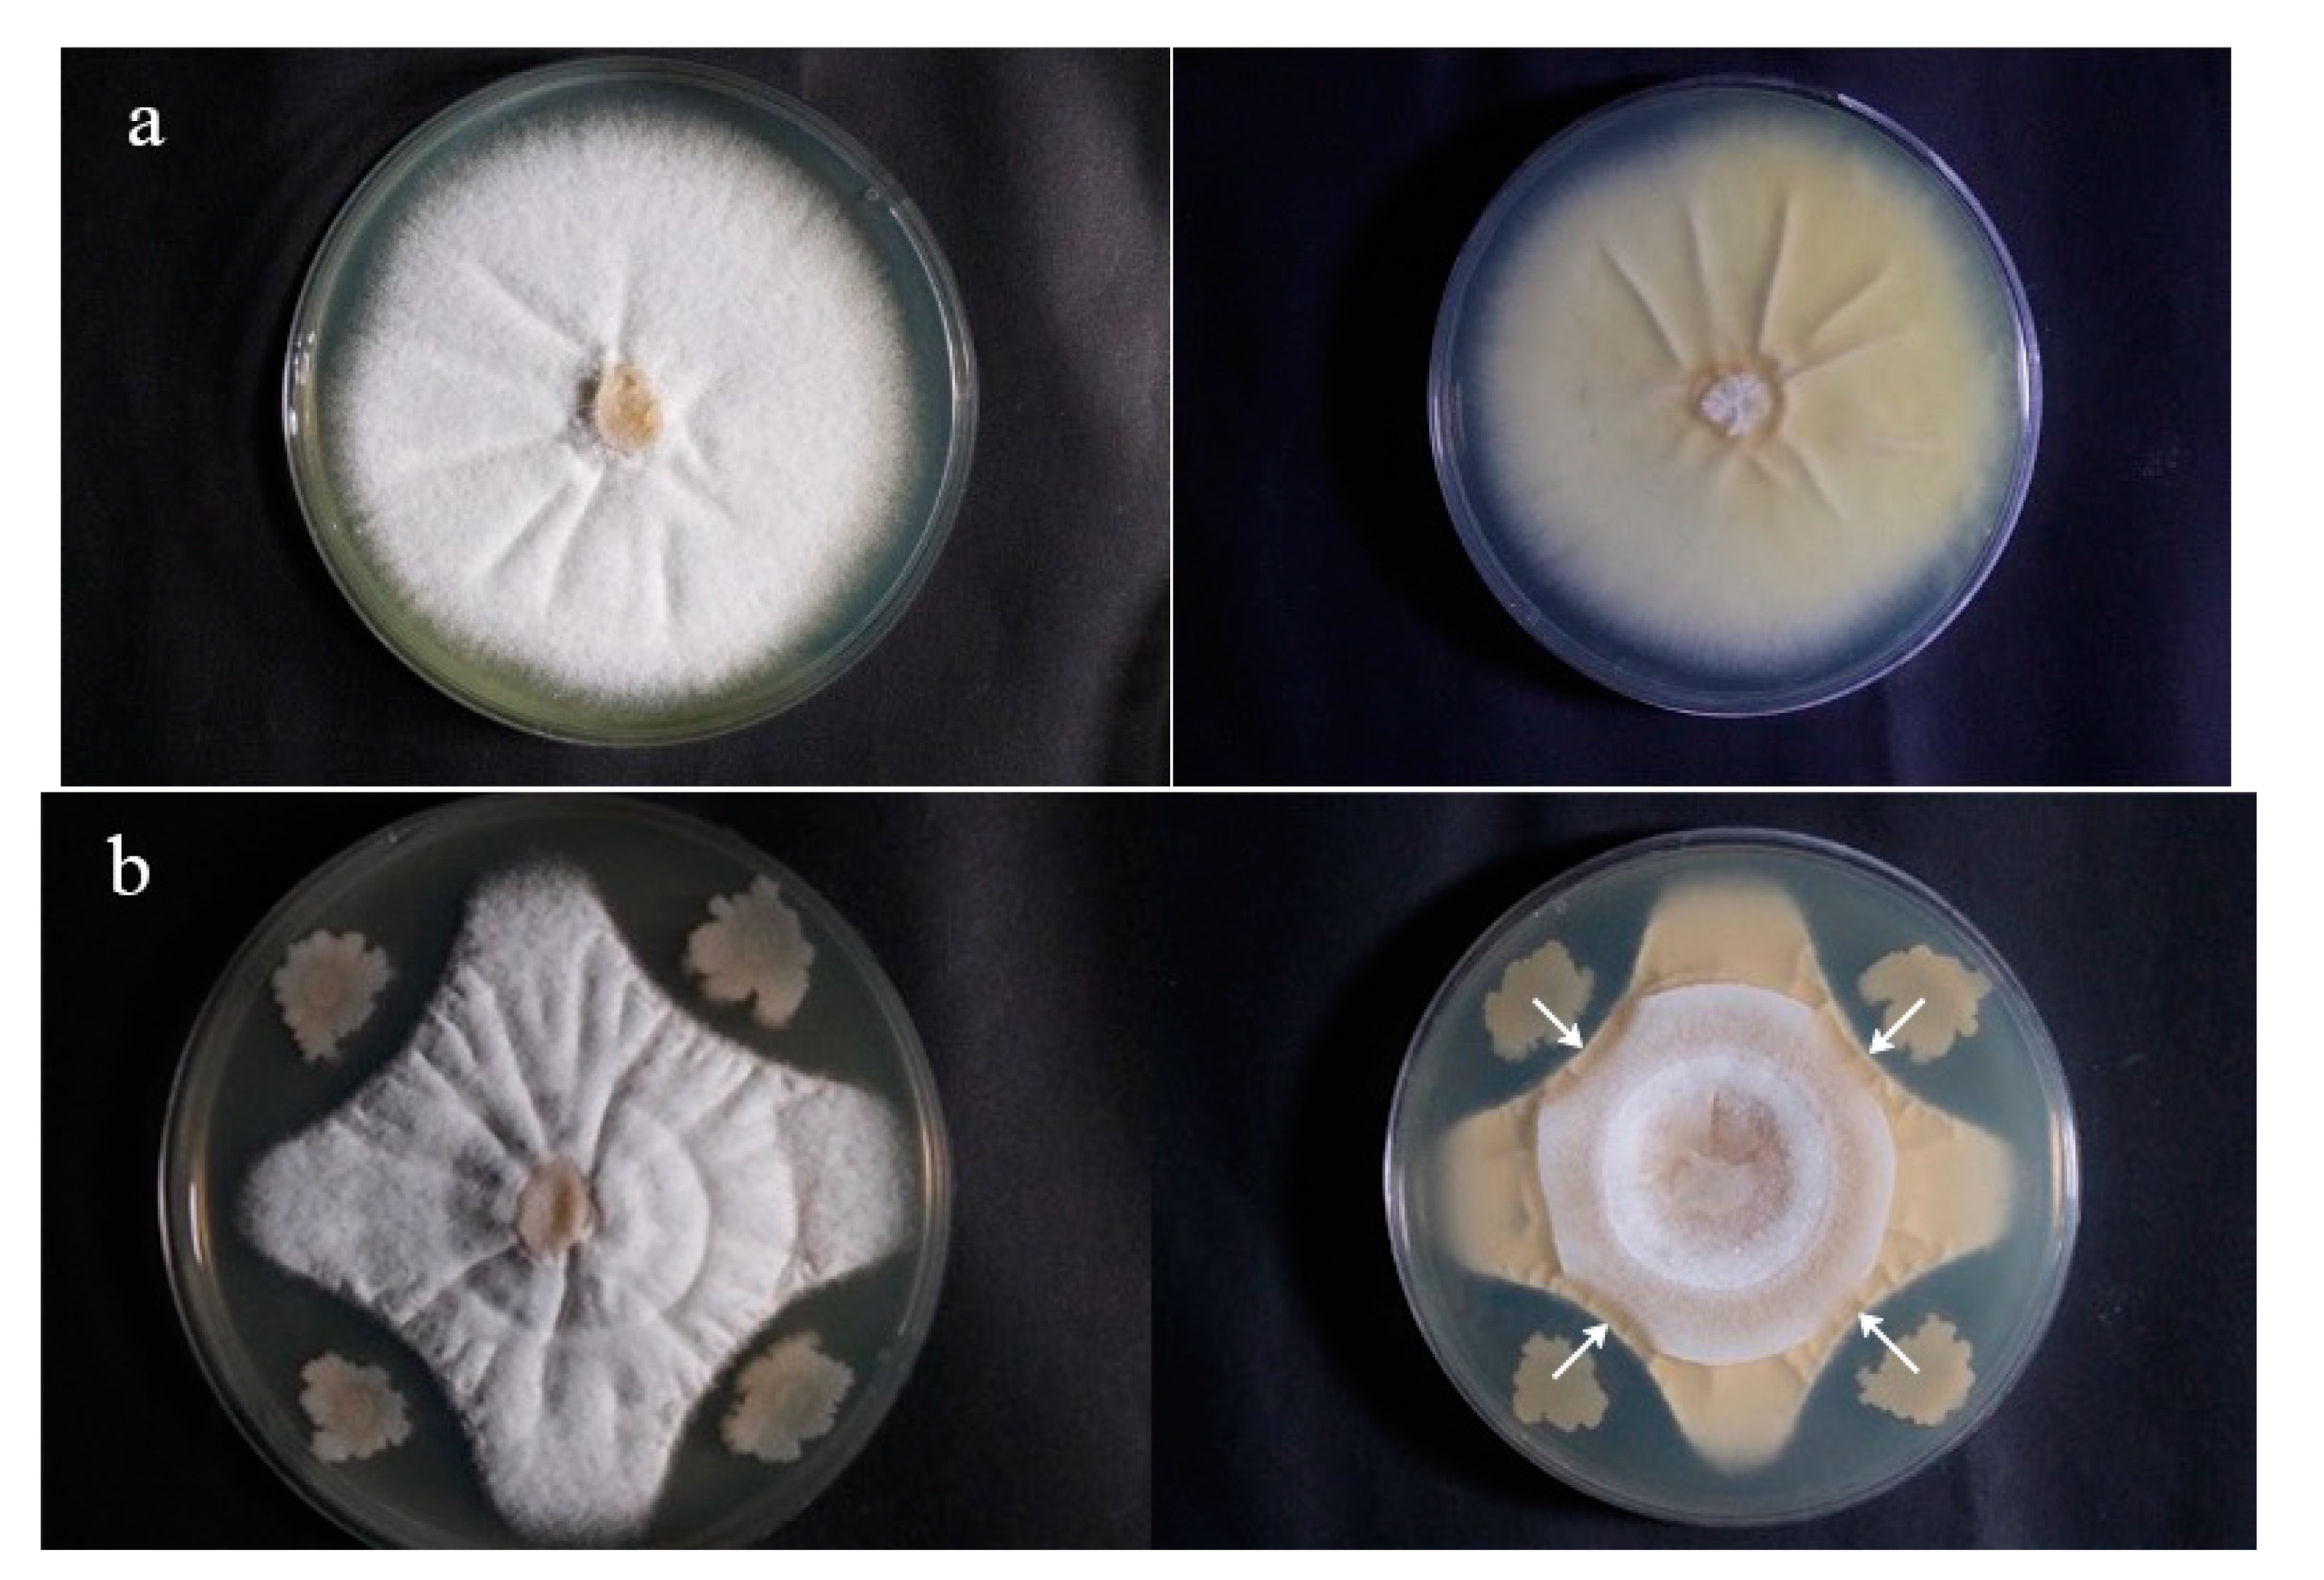
Forests 12 00785 g001 Forests 12 00785 g001
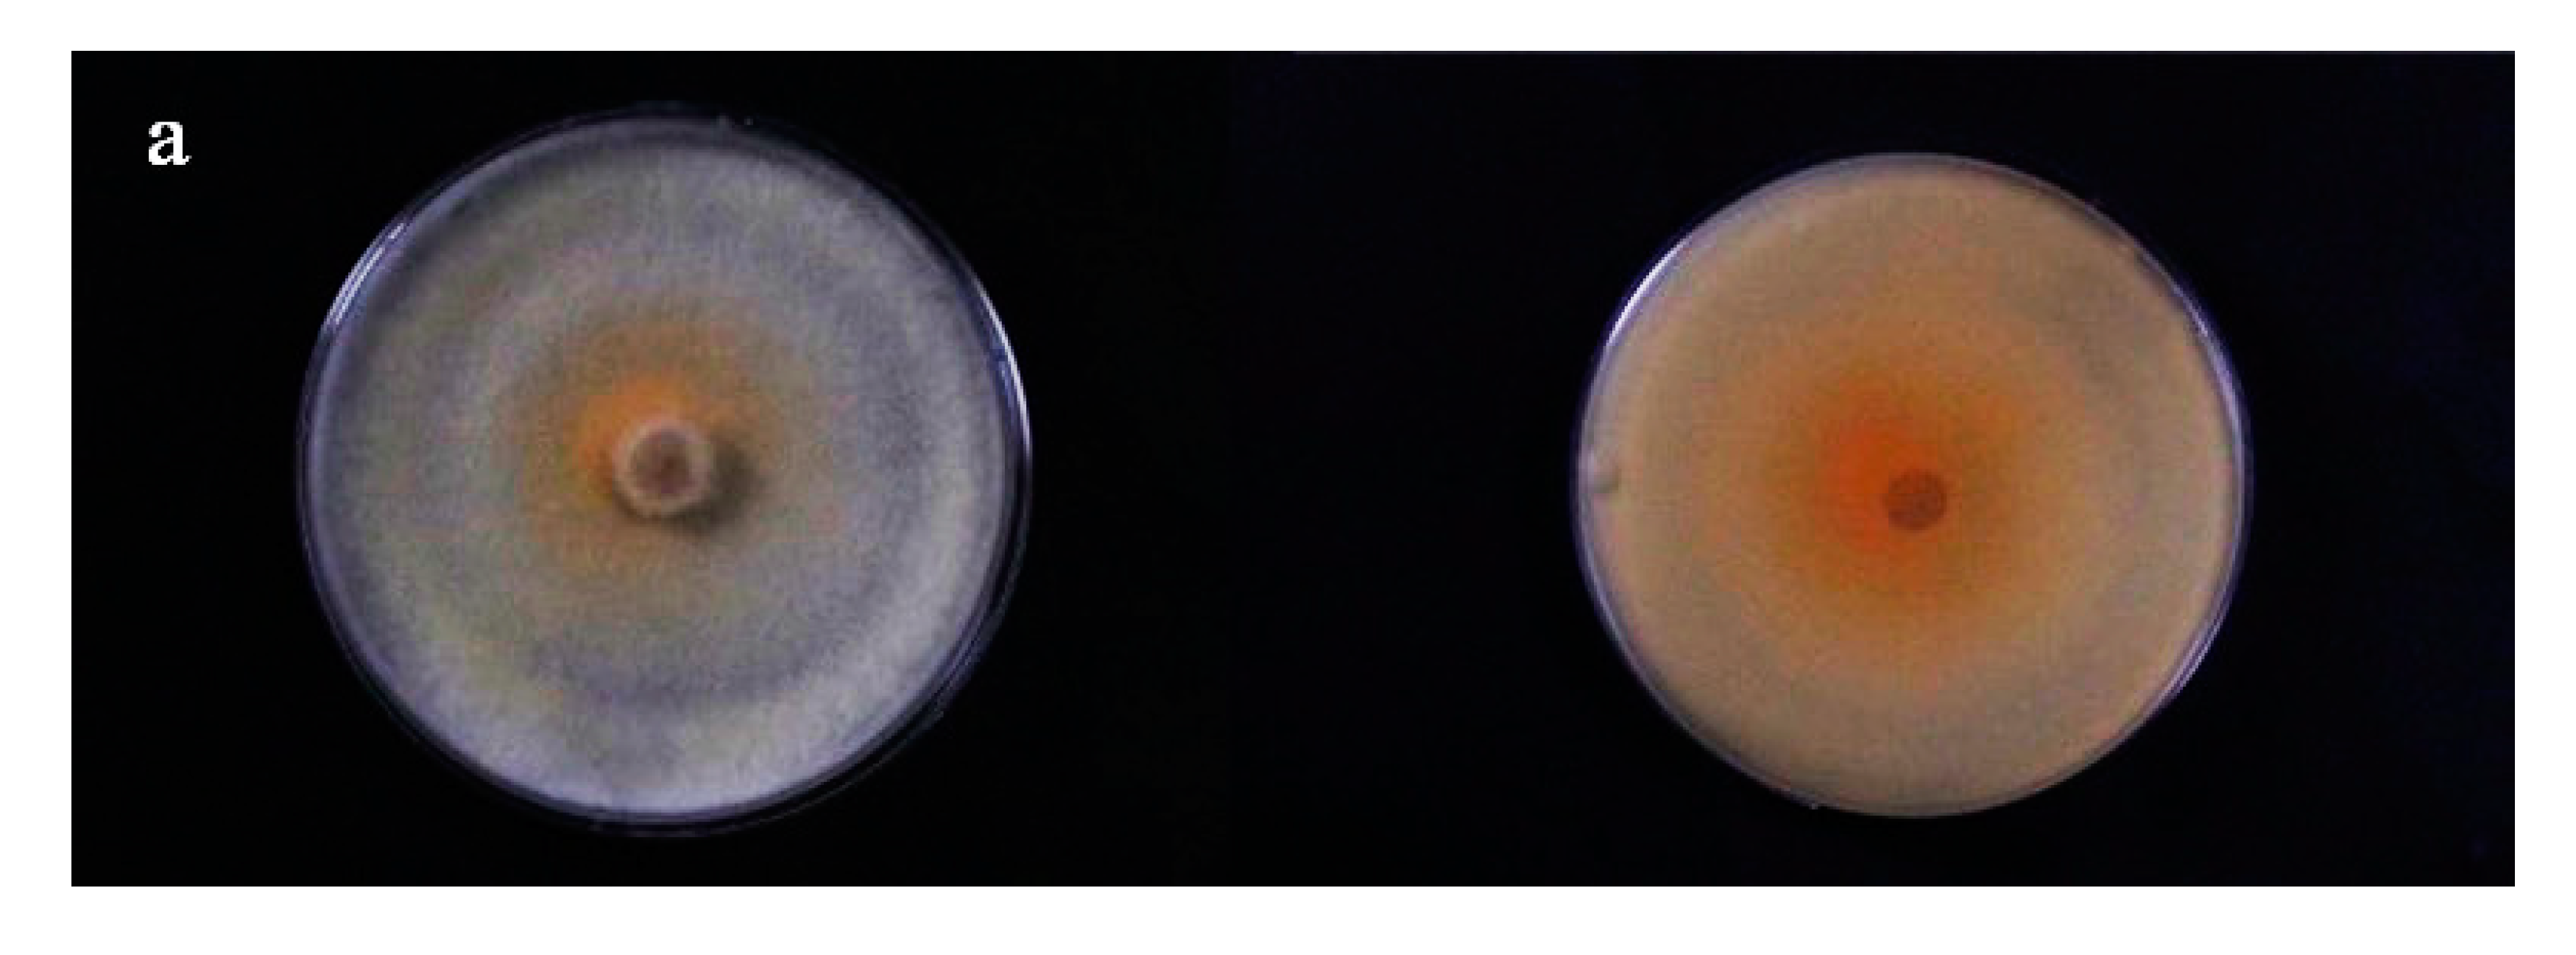
Forests 12 00785 g002a Forests 12 00785 g002a
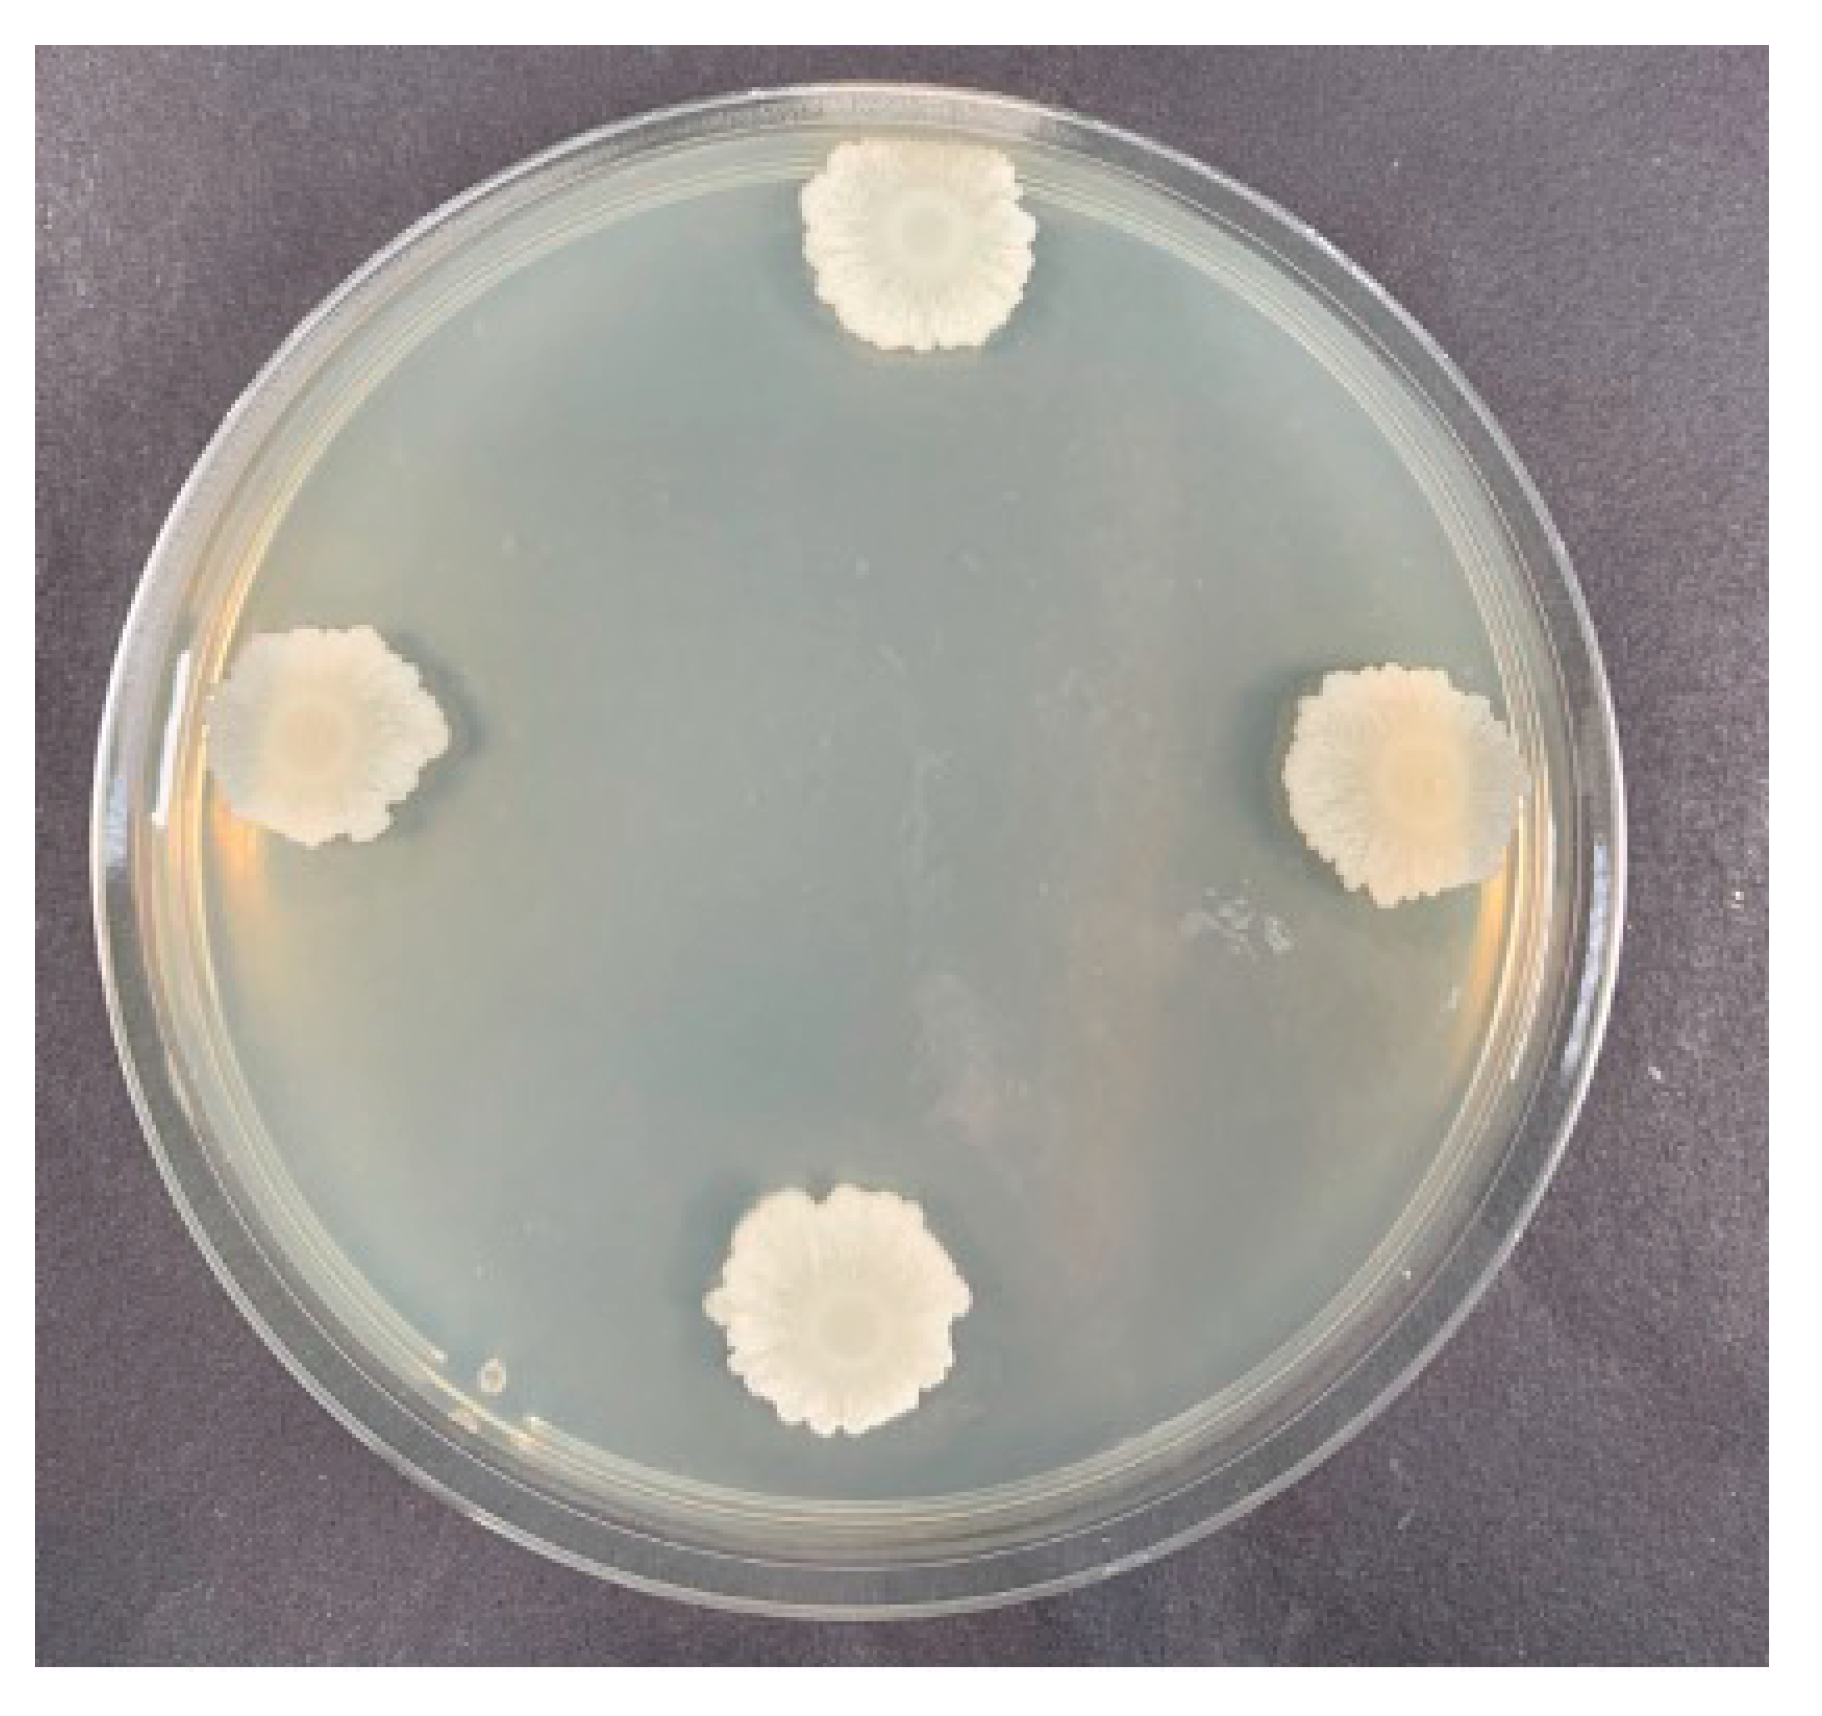
Forests 12 00785 g004 Forests 12 00785 g004

Abstract
(1) Background: Wood decay is a serious issue that results from the presence of wood-destroying fungi and has a great influence on the international wood industry. The utilization of biological control methods offers good prospects for wood preservation. (2) Methods: The plate-screening experiment, the soil block test of the Chinese stand method (GB/T 13942.1), and the characterization of wood blocks were used to achieve biological control of brown rot and white rot. (3) Results: Through isolation, screening, and identification, the antagonistic bacterium Bacillus velezensis Nhw-B72 strain was obtained. In the plate-screening experiment, the inhibition zone diameter of Nhw-B72 for Gloeophyllum trabeum was 1.68 cm and that for Coriolus versicolor was 2.33 cm. After inhibition, the morphology of mycelia was distorted, malformed, and broken. In the soil block test, the average weight loss percentage of wood blocks in the control group was 61.66%. In the treatment group, the average weight loss percentage of the wood blocks with drying was 28.18% and that of the wood blocks without drying was 34.97%. (4) Conclusions: The strain has an obvious antagonistic effect on the wood-destroying fungi and the sterile fermentative liquid can effectively inhibit wood decay. In addition, compared to the drying of wood blocks, the air-drying of blocks after impregnation with the fermentative liquid had a better inhibition effect.
1. Introduction
Wood is widely used in nearly all aspects of people’s lives. Wood decay occurs gradually under natural conditions, especially in humid environments, and a variety of microorganisms are involved in the process [1,2]. Brown rot and white rot are two principal models in the homobasidiomycetes [3]. Brown and white rot fungi showed completely different decomposition patterns in the wood structure [4,5,6]. Brown rot is one of the most common types of wood decay. It has a great influence on wood properties in the later stages of wood decay, and also causes serious economic loss [6,7].
Bacillus has been widely used in many fields as an antagonistic bacteria [8,9,10]. It can produce a variety of antagonistic enzymes and has a broad spectrum of antimicrobial activity [11,12,13]. In addition, Bacillus produces endospores under conditions of nutrient deficiency [14]. Endospores have strong resistance to high temperature, acid and alkali, ultraviolet light, and can withstand a variety of adverse conditions [15]. Therefore, Bacillus has been a concern among both domestic and foreign scholars [8,16]. Sajitha, K. L isolated seven strains of Bacillus from different sources of aerobic composts. These seven strains showed good inhibitory effects on the wood sap-stain fungus Lasiodiplodia theobromae (G. & M.) on rubberwood, indicating that Bacillus is an important source of strains in the field of wood preservation [17]. Devkota conducted an in vitro antibiosis experiment with 27 strains of Bacillus velezensis and plant pathogens from six different genera, and found that Bacillus velezensis has good prevention and control effects against wood sapstain in pine trees and rhizosphere diseases in Pinales [18]. This fact indicates that Bacillus velezensis has potential as a biological control agent for wood preservation. Nevertheless, there is still a lack of knowledge surrounding Bacillus velezensis (R.) in the field of wood preservation.
The main way to prevent wood decay at present is through chemical treatments. Although chemicals are highly effective against wood-destroying fungi, they always leak to some extent, causing environmental pollution and potential harm to human beings [19,20,21]. In today’s society, which has begun to pay increasing attention to human health, environmental protection and ecology have become the key development directions in the field of wood protection [22]. Only biological control measures have these characteristics and, as a result, will become the inevitable trend in wood protection [23]. Bacillus has the advantages of good safety and strong resistance, and can be applied to prevent wood decay.
This study isolated and screened antagonistic bacteria against common wood-destroying fungi from the soil by means of plate-screening experiments and the soil block test (GB/T 13942.1). The purpose was to investigate whether these bacteria strains can be used as a biological control agent for the prevention and control of wood fungal decay.
2. Materials
Landy medium, Luria–Bertani (LB) medium, and potato dextrose agar (PDA) medium were used after autoclaved treatment in the course of the experiment. Eighteen sapwood samples that were free of visible defects were used (Populus ussuriensis Kom.) (Dongfanghong Forest Farm, Harbin, China). The samples were prepared from a board and were cut to 20 mm (R) × 20 mm (L) × 10 mm (T). The wood rot fungi were selected as Coriolus versicolor (Q.) and Gloeophyllum trabeum (M.) (GB/T 13942.1). The source of the wood-destroying fungi was the China Forestry Culture Collection Center (CFCC), and the GenBank accession of the Nhw-B72 strain was no. MW776613.
3. Methods
3.1. Isolation of Antagonistic Bacteria
According to the diagonal principle, a 20 m × 20 m standard plot was set in the forest farm of Northeast Forestry University, and 3 plots of 20 m × 20 m were used to repeat. Five Pinus sylvestris var. were selected according to the Z-shaped curve in each standard plot. In the crown projection, we removed the dead branches, shrubs, and herbaceous vegetation on the soil surface first, and then dug the root system of Pinus sylvestris var. The soils of the rhizosphere of Pinus sylvestris var. were collected by the shaking method. The different soils of the rhizosphere in the same standard soil were mixed into one sample of soil. After collecting the soil, 1 g of screened soil was added into a 50 mL conical flask, and sterile water was added to the volume of 50 mL. The soil suspension was heated to 80 °C for 20 min by means of the water bath method. The supernatant was taken for gradient dilution, and the spread plate method was adopted. After 2 days, single bacterial colonies were isolated according to morphology and other characteristics, and the bacteria were purified and preserved.
3.2. Screening of Antagonistic Bacteria
The antagonistic bacteria were screened by the agar plate-screening method. The purified strains were activated on LB plates and shaken overnight. Then, the bacterial solution was diluted to 1.2 × 108 CFU/mL. Wood-destroying fungi were cultured on one PDA medium, and then a 5 mm small agar disc was made with a hole puncher and placed in the other center of the PDA medium. According to the GB/T 13942.1, Gloeophyllum trabeum was selected as the representative species of brown rot fungi, and Coriolus versicolor was selected as the representative species of white rot fungi. Gloeophyllum trabeum and Coriolus versicolor were cultured on potato dextrose agar medium. With a small agar disc of Gloeophyllum trabeum and Coriolus versicolor as the center, the same bacteria were inoculated 3.5 cm away from the center. Each treatment was repeated three times, and Petri dishes were kept at room temperature. Three Petri dishes with no bacteria were used as controls. Wood-destroying fungi with poor inhibitory effects were selected to observe the growth of mycelia. The inhibition zone of the treatment group was observed, and the diameter of the inhibition zone was calculated until the wood-destroying fungi in the center of the medium of the control group grew to the edge of the medium. The line from the center of the antagonistic bacteria to the center of the wood-destroying fungi had an intersection point with the edge of the wood-destroying fungi. The distance between the intersection points and the center of antagonistic bacteria was the radius of the inhibition zone. After comparing the diameters of the inhibition zone, an antagonistic strain was selected for subsequent experiments. The diameter of the inhibition zone was processed by Microsoft Excel (Microsoft Corp., version16.44, Redmond, WA, USA).
3.3. Identification of the Antagonistic Bacteria
3.3.1. Colony Morphology
The antagonistic strains with good inhibitory effects on wood-decay fungi were activated on LB plates. After culturing for 2 days, various colony morphological features, such as form, size, margin, elevation, and texture, were observed and noted.
3.3.2. PCR Amplification, Sequencing and Phylogenetic Analysis
The genomes of the screened strains were extracted and identified by molecular biology. The 16S rDNA-encoding gene unit was amplified by a polymerase chain reaction (PCR). The total volume of PCR was 20 μL. There was 1 μL of each universal primer 27F (5′-AGAGTTTGATCCTGGCT-CAG-3′) and 1492R (5′-TACGGCTACCTTGTTAC-GACT-3′), 7 μL of the premix, 10 μL of DDH2O, and 1 μL of the template in the system. Amplification was carried out with a preliminary denaturation step at 94 °C for 5 min, followed by denaturation (94 °C for 30 s), primer annealing (55 °C for 30 s), and an extension (72 °C for 90 s). After 30 cycles of PCR amplification, the PCR products were screened by electrophoresis and sent to biotech companies for sequencing. After obtaining the sequence results, the BLAST function of National Center of Biotechnology Information (NCBI) was used for DNA sequence homology alignment. Sequence analysis was conducted with Mega X 10.0.5 software, and a phylogenetic tree was constructed based on the neighbor-joining method of Mega X 10.0.5 software.
3.4. Preparation of Fermentative Liquid of Antagonistic Bacteria
The preserved purified strain was activated on an LB plate and shaken overnight, and the bacterial solution was diluted to 1.2 × 108 CFU/mL. Six conical flasks were placed in 100 mL of Landy medium, and 10 mL of bacterial liquid from each 1000 mL conical flask was placed into a shaker for 60 h and removed. The bacterial liquid was centrifuged twice at 13,000 rpm for 20 min at 4 °C, and the supernatant was filtered through a bacterial liquid filter.
3.5. Pretreatment of Wood Blocks
The sapwood lumber of Populus ussuriensis that was free of visible defects was cut into 18 blocks (20 mm × 20 mm × 10 mm) and oven-dried at 103 °C until reaching a constant weight. The wood blocks were numbered and steam sterilized for 30 min at 121 °C. The 12 wood blocks were soaked in the prepared sterile fermentative liquid for 20 min and then removed. Six wood blocks were air-dried and six wood blocks were undried.
3.6. Soil Block Test
According to the method for laboratory test of natural decay resistance (GB/T 13942.1), wood blocks treated with sterile fermentative liquid were used to perform the soil block test. The media of the soil block test were prepared, and a feeder strip was placed on the soil surface. The media were autoclaved for 45 min at 121 °C. After cooling, a small agar disc cut from the edge of a growing culture of Gloeophyllum trabeum was placed on the feeder strip surface, next to the feeder strip. When the feeder strips were covered with wood-destroying fungi, the soaked and unsoaked wood blocks were placed on top of the feeder strips. The mediums were incubated at 28 °C for 12 weeks. After 12 weeks, blocks were removed from the media and scraped clean of adhering soil and mycelium. Blocks were then oven-dried at 60 °C and weighed to determine mass loss during the fungal exposure period. These data were processed by Microsoft Excel (Microsoft Corp., version16.44, Redmond, WA, USA) and imported into Origin (Origin Lab, version 2018, Northampton, MA, USA) for drawing. The significance analysis was performed using Origin software (Origin Lab, version 2018, Northampton, MA, USA).
3.7. Characterization of Wood Block
Scanning electron microscopy (SEM, Quanta200, FEI Co., Hillsboro, OR, USA) was used to analyze the microscopic morphology of the samples without impregnation and those impregnated for 20 min. The treated samples were cut into small pieces (8 mm (R) × 8 mm (T) × 1 mm (L)). The small samples were sputter-coated with gold. The acceleration voltage was set to 5 kV, the beam spot size was 8, and the working distance was 10 mm. The degree of block decay in the treatment group and control group was observed.
4. Results
4.1. Isolation and Screening of Antagonistic Bacteria
In the forest farm of Northeast Forestry University, 81 strains of bacteria were isolated according to colony morphology and other characteristics. The isolated strains were subjected to a plate-screening experiment with Coriolus versicolor; several strains had certain inhibitory effects on Coriolus versicolor, among which B1, B2, B3, B4, B28, B29, B72, and B81 strains had obvious inhibitory zones on Coriolus versicolor. The diameter of the inhibition zone is shown in Table 1 and Table A1. By comparison, the diameter of the inhibition zone of B72 was the largest at 2.33 cm. As shown in Figure 1, B72 formed an obvious inhibition zone against Coriolus versicolor, which had the best inhibition effect.
Table 1.
Diameter of the inhibition zone of the strains against Coriolus versicolor and Gloeophyllum trabeum.
Figure 1.
(a) The control group of Coriolus versicolor. (b) The inhibition zones produced by B72 strain against Coriolus versicolor.
The isolated strains were subjected to a plate-screening experiment with Gloeophyllum trabeum, where the B1, B2, B3, B4, B28, B29, B72, B80, and B81 strains showed obvious inhibitory zones against Gloeophyllum trabeum. The diameter of the inhibition zone is shown in Table 1 and Table A2. By comparison, the diameter of the inhibition zone of B72 was the largest. The diameter of the inhibition zone of B72 was 1.68 cm.
As shown in Figure 2, B72 formed an obvious inhibition zone against Gloeophyllum trabeum, which had the best inhibition effect. Gloeophyllum trabeum was selected to observe the mycelia. The mycelia of Gloeophyllum trabeum inhibited by B72 were distorted, malformed, and broken (Figure 3).

Figure 2.
(a) The control group of Gloeophyllum trabeum. (b) The Inhibition zones produced by B72 strain against Gloeophyllum trabeum.
Figure 3.
(a) The mycelia of Gloeophyllum trabeum of the control group. (b) The mycelia of Gloeophyllum trabeum of the treatment group. (1. Broken mycelia. 2. Thickened mycelia. 3. Malformed and distorted mycelia. 4. Leakage of protoplasm).
4.2. The Result of Identification of Antagonistic Bacteria
The B72 strain was activated and cultured in LB medium for 48 h. The colony of strain B72 was observed. As shown in Figure 4, the colony of strain B72 was round and slightly yellow, with a relatively smooth surface, a few folds, and irregular edges.
Figure 4.
Morphology of the colony of strain B72.
The isolated strain B72 was identified based on 16S rDNA gene sequence analysis. The 16S rDNA sequence of strain B72 was put into the NCBI database for BLAST analysis to find similar strains with high homology. The B72 strain showed a 99% sequence homology to the 16S rDNA gene sequence of Bacillus velezensis BvL03 (GenBank accession no. MN093810.1). The phylogram showing genetic similarities displayed a major clade with the isolated strain and the most similar accessions from the NCBI GenBank. Phylogenetic trees were constructed using Mega X 10.0.5 software. As shown in Figure 5, the Pantoea agglomerans strain DSM 3493 was used as the outgroup in the phylogenetic tree. The B72 strain was clustered in the same branch as the Bacillus velezensis strain BvL03. The genetic distance of the branch was the closest, and the support rate was 99%. Based on the results of similarity comparison and morphological characteristics, the B72 strain was identified as Bacillus velezensis. The 16S rDNA gene sequence of B72 was deposited into the NCBI GenBank (GenBank accession no. MW776613).
Figure 5.
The phylogenetic tree of B72 strain.
4.3. Inhibitory Effect of Sterile Fermentative Liquid on Wood Decay
4.3.1. External Morphology of the Blocks
After 12 weeks of culture, the blocks were observed. As shown in Figure 6, the surface of blocks that were not soaked in sterile fermentative liquid was completely covered by colonies of wood-destroying fungi. The thickness of colonies of wood-destroying fungi was approximately 3 mm, as measured on a scale. The surface of the block that was soaked in the sterile fermentative liquid and air-dried basically had no mycelium, while the surface of the block that was soaked in the sterile fermentative liquid but not air-dried was covered with a thin layer of mycelium. After the blocks were soaked in sterile fermentative liquid, the mycelia on the dried blocks were different from those on the undried blocks. The thickness of the mycelium on the surface of the undried block was slightly greater, and the thickness of the colony of the wood-destroying fungus was approximately 1 mm.
Figure 6.
(a) Dried blocks soaked in sterile fermentative liquid after 12 weeks. (b) Undried blocks soaked in sterile fermentative liquid after 12 weeks. (c) Blocks not soaked in sterile fermentative liquid after 12 weeks.
After the mycelia were scraped off, the wood blocks of the control group and the treatment group were dried and weighed. The loss of mass and the percentage of block decay are shown in Figure 7. The average weight loss of wood blocks in the control group was 1.137 g, the average weight loss of wood blocks in the dry group was 0.532 g, and the average weight loss of wood blocks in the undried group was 0.657 g. The average weight loss percentage of wood blocks in the control group was 61.66%. In the treatment group, the average weight loss percentage of the wood blocks with drying was 28.18% and that of the wood blocks without drying was 34.97%. As can be seen from the significance analysis results in Figure 7, the average weight loss of wood blocks in the control group and the average weight loss of wood blocks in the dry group showed significant a difference. There was also a significant difference between the average weight loss of wood blocks in the control group and the average weight loss of wood blocks in the undried group.
Figure 7.
The degree of wood block decay in the treatment group and control group. * indicates no significant difference and ** indicates a significant difference.
4.3.2. Internal Morphology of the Blocks
As shown in Figure 8, the interior of blocks that were not soaked in sterile fermentative liquid had a lot of mycelia. Because the wood-destroying fungi colonized the wood, there were many mycelia inside the wood. The internal morphology of the undried blocks that were soaked in the sterile fermentative liquid after 12 weeks is shown in Figure 9. The mycelia in the wood-destroying fungi were reduced, but some mycelia were still attached to the wood interior. The dried blocks that soaked in the sterile fermentative liquid after 12 weeks are shown in Figure 10. The mycelia of wood-destroying fungi could not be observed inside the wood.
Figure 8.
The internal morphology of the control group.
Figure 9.
The internal morphology of the undried blocks.
Figure 10.
The internal morphology of the dried blocks.
5. Discussion
At present, research on the use of microorganisms and their fermentation products for wood preservation mainly focuses on preventing wood sapstain [24,25,26]. This study was the first attempt to inhibit wood decay by brown and white rot fungi using a sterile fermentative liquid of microorganisms. In this study, the screened Bacillus velezensis Nhw-B72 was used to test the inhibition of wood-destroying fungi on plates. Bacillus velezensis Nhw-B72 showed an obvious inhibition zone against Gloeophyllum trabeum and Coriolus versicolor, indicating potential inhibitory effects. The plate-screening experiment was performed under ideal conditions, and the soil block test was used to further explore the antifungal properties of Bacillus velezensis Nhw-B72. The result of the soil block test was consistent with the result of the plate-screening experiment, which indicated that the strain deserves further investigation.
According to the diameters of the inhibition zone obtained by the plate-screening experiment with Gloeophyllum trabeum and Coriolus versicolor, the average diameters of the inhibition zone obtained by plate screening with Coriolus versicolor was 0.6 cm larger than that of Gloeophyllum trabeum. When Gloeophyllum trabeum was used as the opposing strain, the inhibition zone diameters of both B28 and Nhw-B72 strains were greater than 1.6 cm. The effect of the two strains on the plate was basically the same, but strain B28 did not show an inhibition zone when Coriolus versicolor was used as the opposing strain. When Coriolus versicolor was used as the opposing strain, the inhibitory zone diameters of the B2, B3, B4, B81, and Nhw-B72 strains were all greater than 2.2 cm, but the inhibitory zone formed by the B2, B3, B4, and B81 strains was too small compared to Gloeophyllum trabeum on the plate. B28 and B29 strains also have good antagonistic effects, as shown in the Table 1. By morphological identification and 16S rDNA identification, the B28 strain was Bacillus subtilis, and the B29 strain was Bacillus amyloliquefaciens.
Some Bacillus can produce a variety of antagonistic enzymes, such as β-1,3-glucanase, cellulase, and protease [27,28]. The cell wall of fungi is damaged under the action of these enzymes, which is one of the most important mechanisms of Bacillus against fungal diseases [13,29]. Velmurugan [30] isolated high-activity antifungal lipopeptides against Ophiostoma flexuosum, Ophiostoma tetropii, Ophiostoma polonicum, and Ophiostoma ips from Bacillus subtilis and Bacillus licheniformis. The isolated lipopeptides may belong to the surfactin and iturin family. Possible mechanisms between the antagonistic activity of lipopeptides and fungal samples have also been discussed [31]. The mycelia of wood-destroying fungi after the plate-screening experiment with Nhw-B72 in this study were observed, and the mycelia were found to be malformed and broken. It was speculated that this was because Bacillus velezensis Nhw-B72 produced some active substance, which destroyed the cell wall of mycelia and thus inhibited the growth of mycelia.
After 12 weeks, the air-dried blocks in Figure 6a had almost no mycelia. The average percentage of wood decay was only 28.18%. The surfaces of the blocks in Figure 6c were completely covered by wood rot fungus colonies. The average percentage of block decayed was 61.66%. Figure 6a compared with Figure 6c shows that the sterile fermentative liquid of strain Nhw-B72 can effectively inhibit the growth of mycelia of wood-destroying fungi on the wood block. The undried blocks in Figure 6b were covered by a few mycelia. The average percentage of block decayed was 34.97%. In Figure 6a, compared with Figure 6b, it could be concluded that drying the blocks after being soaked in sterile fermentative liquid will affect the inhibition effect, and that the dried method is better than the undried method in inhibiting wood decay.
6. Conclusions
In this study, the Nhw-B72 strain was isolated and screened from the soil under decaying Pinus sylvestris var. It was confirmed that the strain had an obvious inhibitory effect on Gloeophyllum trabeum and Coriolus versicolor by the plate-screening method. The soil block test using the sterile fermentative liquid of Bacillus velezensis showed that the sterile fermentative liquid of strain Nhw-B72 could effectively inhibit wood decay. In addition, the air-drying of blocks after impregnation with the fermentative liquid increased the inhibition effect. These conclusions can provide a theoretical basis for production practice.
Author Contributions
Conceptualization, G.X. and L.W.; methodology, P.Z. (Ping Zhang); software, C.H.; validation, C.H., P.Z. (Pengwei Zhao) and Y.Z.; formal analysis, C.H.; investigation, C.H.; resources, G.X.; data curation, C.H.; writing—original draft preparation, C.H.; writing—review and editing, G.X.; visualization, C.H.; supervision, G.X.; project administration, G.X.; funding acquisition, G.X. All authors have read and agreed to the published version of the manuscript.
Funding
This research was funded by the Natural Science Foundation of China, grant number 31500470; the Natural Science Foundation of Heilongjiang Province, China, grant number C2016014 and The APC was funded by guoqi xu.
Acknowledgments
The State Key Laboratory of Tree Genetics and Breeding of Northeast Forestry University and Ben Niu for his help in interpreting the significance of the results.
Conflicts of Interest
The authors declare no conflict of interest.
Appendix A
Table A1.
Diameter of the inhibition zone of the strains against Coriolus versicolor. The data in one row are three sets of replicates of the same strain.
Table A1.
Diameter of the inhibition zone of the strains against Coriolus versicolor. The data in one row are three sets of replicates of the same strain.
| Numbers of the Confronting Strains of CV | 1 | 2 | 3 | 4 | 1 | 2 | 3 | 4 | 1 | 2 | 3 | 4 | Average |
|---|---|---|---|---|---|---|---|---|---|---|---|---|---|
| 1 | 2.4 | 2.2 | 2.2 | 1.9 | 2.2 | 2.4 | 2 | 1.9 | 2.2 | 2.3 | 2.3 | 2.1 | 2.18 |
| 2 | 2.1 | 2.2 | 2 | 2.4 | 2.5 | 2.2 | 2.3 | 2.4 | 2.2 | 2.2 | 2.4 | 1.9 | 2.23 |
| 3 | 2.2 | 2.5 | 2.3 | 2.2 | 2 | 2.3 | 2.3 | 2.1 | 2 | 2.5 | 2.1 | 2.3 | 2.23 |
| 4 | 2.3 | 2.1 | 2.4 | 2.2 | 2.7 | 2.4 | 2.2 | 2.1 | 2.2 | 2.2 | 2.4 | 1.9 | 2.26 |
| 28 | 2 | 2.1 | 2 | 2.1 | 2.1 | 2.5 | 2.4 | 2 | 2 | 1.9 | 2.1 | 2.4 | 2.13 |
| 29 | 1.5 | 1.9 | 1.3 | 2 | 2.2 | 1.8 | 1.7 | 1.9 | 1.9 | 2 | 1.9 | 1.7 | 1.82 |
| 72 | 2.2 | 2.4 | 2.2 | 2.3 | 2.1 | 2.1 | 2.6 | 2.6 | 2.4 | 2.3 | 2.4 | 2.3 | 2.33 |
| 80 | 1.6 | 1.7 | 1.7 | 1.5 | 2 | 1.9 | 1.9 | 1.9 | 1.8 | 2 | 1.9 | 1.5 | 1.78 |
| 81 | 2.5 | 2.3 | 2.1 | 2.1 | 2.3 | 2.2 | 1.9 | 2.2 | 2.2 | 2.3 | 2.3 | 2.2 | 2.22 |
Table A2.
Diameter of the inhibition zone of the strains against Gloeophyllum trabeum. The data in one row are three sets of replicates of the same strain.
Table A2.
Diameter of the inhibition zone of the strains against Gloeophyllum trabeum. The data in one row are three sets of replicates of the same strain.
| Numbers of the Confronting Strains of GT | 1 | 2 | 3 | 4 | 1 | 2 | 3 | 4 | 1 | 2 | 3 | 4 | Average |
|---|---|---|---|---|---|---|---|---|---|---|---|---|---|
| 5 | 1.2 | 1.3 | 1.7 | 1.7 | 1.3 | 1.3 | 1.5 | 1.5 | 1.6 | 1.3 | 1.1 | 1.5 | 1.42 |
| 6 | 1.5 | 1.4 | 1.7 | 1.8 | 1.9 | 1.3 | 1.5 | 1.9 | 1.4 | 1.4 | 1.2 | 1.2 | 1.52 |
| 8 | 1.8 | 1.6 | 1.3 | 1.5 | 1.5 | 1.5 | 1.4 | 1.5 | 1.3 | 1.5 | 1.9 | 1.6 | 1.53 |
| 10 | 1.9 | 1.6 | 1.1 | 1.5 | 1.7 | 1.7 | 1.3 | 1.3 | 1.5 | 1.3 | 1.1 | 1.1 | 1.43 |
| 11 | 1.4 | 1.3 | 1.6 | 1.1 | 1.8 | 1.5 | 1.4 | 1.7 | 1.5 | 1.1 | 1.3 | 0.5 | 1.35 |
| 12 | 1.3 | 1.4 | 1.4 | 1.5 | 1.4 | 1.4 | 1.5 | 1.1 | 1.5 | 1.3 | 1 | 1.1 | 1.33 |
| 13 | 1.5 | 1.4 | 1.3 | 1.2 | 1.2 | 1.4 | 1.4 | 1.2 | 1.9 | 1.9 | 1.7 | 1.5 | 1.47 |
| 15 | 1.7 | 1.5 | 1.7 | 2 | 1.7 | 1.5 | 1.8 | 0.3 | 1.4 | 1.8 | 1.8 | 1.2 | 1.53 |
| 25 | 1.9 | 1.6 | 1.5 | 1.7 | 1.4 | 1.4 | 1.8 | 1.6 | 1.7 | 1.6 | 1.7 | 1.7 | 1.63 |
| 28 | 1.4 | 1.1 | 1.8 | 1.5 | 1.5 | 1.6 | 1.7 | 1.6 | 1.7 | 1.7 | 1.4 | 1.2 | 1.52 |
| 29 | 1.5 | 1.4 | 1.3 | 1.4 | 1.7 | 1.5 | 1.6 | 1.7 | 1.5 | 1.6 | 1.5 | 1.2 | 1.49 |
| 72 | 1.8 | 1.7 | 1.6 | 1.6 | 1.6 | 1.5 | 1.5 | 1.6 | 1.9 | 1.9 | 1.8 | 1.7 | 1.68 |
| 81 | 1.4 | 1.7 | 1.2 | 1.1 | 1.3 | 1.2 | 1.3 | 0 | 1.3 | 1.2 | 1.3 | 1.6 | 1.22 |
References
- Eaton, R.A.; Hale, M.D.C. Wood: Decay, Pests and Protection; Chapman & Hall: Cambridge, UK, 1993. [Google Scholar]
- Ibach, R. Biological properties. In Wood Chemistry and Wood Composites; Rowell, R.M., Ed.; Taylor & Francis: Boca Raton, FL, USA, 2005. [Google Scholar]
- Hibbett, D.S.; Donoghue, M.J. Analysis of character correlations among wood decay mechanisms, mating systems, and substrate ranges in homobasidiomycetes. Syst. Biol. 2001, 50, 215–242. [Google Scholar] [CrossRef] [PubMed]
- Rayner, A.; Boddy, L. Fungal decomposition of wood: Its biology and ecology. Q. Rev. Biol. 1988, 73, 1796–1803. [Google Scholar]
- Martinez, A.T.; Speranza, M.; Ruiz-Duenas, F.J.; Ferreira, P.; Camarero, S.; Guillen, F.; Martinez, M.J.; Gutierrez, A.; del Rio, J.C. Biodegradation of lignocellulosics: Microbial chemical, and enzymatic aspects of the fungal attack of lignin. Int. Microbiol. 2005, 8, 195–204. [Google Scholar] [CrossRef] [PubMed]
- Goodell, B. Brown-rot fungal degradation of wood: Our evolving view. In Wood Deterioration and Preservation: Advances in Our Changing World; Acs Symposium Series; Goodell, B., Nicholas, D.D., Schultz, T.P., Eds.; American Chemical Society: Washington, DC, USA, 2003; pp. 97–118. [Google Scholar]
- Schmidt, O. Indoor wood-decay basidiomycetes: Damage, causal fungi, physiology, identification and characterization, prevention and control. Mycol Prog. 2007, 6, 261–279. [Google Scholar] [CrossRef]
- Feio, S.S.; Barbosa, A.; Cabrita, M.; Nunes, L.; Esteves, A.; Roseiro, J.C.; Curto, M.J.M. Antifungal activity of Bacillus subtilis 355 against wood-surface contaminant fungi. J. Ind. Microbiol. Biotechnol. 2004, 31, 199–203. [Google Scholar] [CrossRef]
- Ongena, M.; Jacques, P. Bacillus lipopeptides: Versatile weapons for plant disease biocontrol. Trends Microbiol. 2008, 16, 115–125. [Google Scholar] [CrossRef]
- Du, X.; Zhao, K.; Zhao, Z.; Zhao, J. Progress on Bacillus subtilis microbial ecological agents by fermentation. Microbiol. China 2020, 47, 903–914. [Google Scholar] [CrossRef]
- Xu, W.F.; Ren, H.S.; Ou, T.; Lei, T.; Wei, J.H.; Huang, C.S.; Li, T.; Strobel, G.; Zhou, Z.Y.; Xie, J. Genomic and functional characterization of the endophytic Bacillus subtilis 7PJ-16 strain, a potential biocontrol agent of Mulberry Fruit Sclerotiniose. Microb. Ecol. 2019, 77, 651–663. [Google Scholar] [CrossRef]
- Guo, S.Y.; Li, X.Y.; He, P.F.; Ho, H.H.; Wu, Y.X.; He, Y.Q. Whole-genome sequencing of Bacillus subtilis XF-1 reveals mechanisms for biological control and multiple beneficial properties in plants. J. Ind. Microbiol. Biotechnol. 2015, 42, 925–937. [Google Scholar] [CrossRef]
- Liu, S.; Rich, J.O.; Anderson, A. Antibacterial activity of a cell wall hydrolase from Lactobacillus paracasei NRRL B-50314 produced by recombinant Bacillus megaterium. J. Ind. Microbiol. Biotechnol. 2015, 42, 229–235. [Google Scholar] [CrossRef]
- Nicholson, W.L. Roles of Bacillus endospores in the environment. Cell. Mol. Life Sci. 2002, 59, 410–416. [Google Scholar] [CrossRef]
- Li, Z.; Schottroff, F.; Simpson, D.J.; Ganzle, M.G. The Copy Number of the spoVA(2mob) Operon Determines Pressure Resistance of Bacillus Endospores. Appl. Environ. Microbiol. 2019, 85. [Google Scholar] [CrossRef]
- Zhang, P.; Li, C.; Zhao, Q.; Wang, L.; Ma, L. Inhibition effects of biocontrol bacteria strains on the pathogen of Camellia oleifera anthracnose. J. Beijing For. Univ. 2020, 42, 107–116. [Google Scholar]
- Sajitha, K.L.; Florence, E.J.M.; Dev, S.A. Screening of bacterial biocontrols against sapstain fungus (Lasiodiplodia theobromae Pat.) of rubberwood (Hevea brasiliensis Muell. Arg.). Res. Microbiol. 2014, 165, 541–548. [Google Scholar] [CrossRef]
- Devkota, P.; Kloepper, J.W.; Enebak, S.A.; Eckhardt, L.G. Towards biocontrol of ophiostomatoid fungi by plant growth-promoting rhizobacteria. Biocontrol Sci. Technol. 2020, 30, 19–32. [Google Scholar] [CrossRef]
- Hingston, J.A.; Collins, C.D.; Murphy, R.J.; Lester, J.N. Leaching of chromated copper arsenate wood preservatives: A review. Environ. Pollut. 2001, 111, 53–66. [Google Scholar] [CrossRef]
- Helsen, L.; Van den Bulck, E. Review of disposal technologies for chromated copper arsenate (CCA) treated wood waste, with detailed analyses of thermochemical conversion processes. Environ. Pollut. 2005, 134, 301–314. [Google Scholar] [CrossRef] [PubMed]
- Civardi, C.; Schwarze, F.W.M.R.; Wick, P. Micronized copper wood preservatives: An efficiency and potential health risk assessment for copper-based nanoparticles. Environ. Pollut. 2015, 200, 126–132. [Google Scholar] [CrossRef] [PubMed]
- Mai, C.; Kues, U.; Militz, H. Biotechnology in the wood industry. Appl. Microbiol. Biotechnol. 2004, 63, 477–494. [Google Scholar] [CrossRef]
- Susi, P.; Aktuganov, G.; Himanen, J.; Korpela, T. Biological control of wood decay against fungal infection. J. Environ. Manag. 2011, 92, 1681–1689. [Google Scholar] [CrossRef]
- Caldeira, A.T.; Feio, S.S.; Arteiro, J.M.S.; Roseiro, J.C. Bacillus amyloliquefaciens CCMI 1051 in vitro activity against wood contaminant fungi. Ann. Microbiol. 2007, 57, 29–33. [Google Scholar] [CrossRef]
- Sajitha, K.L.; Dev, S.A. Quantification of antifungal lipopeptide gene expression levels in Bacillus subtilis B1 during antagonism against sapstain fungus on rubberwood. Biol. Control 2016, 96, 78–85. [Google Scholar] [CrossRef]
- Sajitha, K.L.; Dev, S.A.; Florence, E.J. Biocontrol potential of Bacillus subtilis B1 against sapstain fungus in rubber wood. Eur. J. Plant. Pathol. 2018, 150, 237–244. [Google Scholar] [CrossRef]
- Horikoshi, K.; Koffler, H.; Arima, K. Purification and properties of beta-1,3-glucanase from the "lytic enzyme" of Bacillus circulans. AcBB 1963, 73, 267–275. [Google Scholar] [CrossRef]
- Reusch, V.M., Jr.; Hale, S.G.; Hurly, B.J. Levels of cell wall enzymes in endospores and vegetative cells of Bacillus subtilis. J. Bacteriol. 1982, 152, 1147–1153. [Google Scholar] [CrossRef]
- Stein, T. Bacillus subtilis antibiotics: Structures, syntheses and specific functions. Mol. Microbiol. 2005, 56, 845–857. [Google Scholar] [CrossRef] [PubMed]
- Velmurugan, N.; Choi, M.S.; Han, S.S.; Lee, Y.S. Evaluation of antagonistic activities of Bacillus subtilis and Bacillus licheniformis against wood-staining fungi: In vitro and in vivo experiments. J. Microbiol. 2009, 47, 385–392. [Google Scholar] [CrossRef]
- Melent’ev, A.I.; Helisto, P.; Kuz’mina, L.Y.; Galimzyanova, N.F.; Aktuganov, G.E.; Korpela, T. Use of antagonistic bacilli for biocontrol of fungi degrading fresh wood. Appl. Biochem. Microbiol. 2006, 42, 62–66. [Google Scholar] [CrossRef]
Publisher’s Note: MDPI stays neutral with regard to jurisdictional claims in published maps and institutional affiliations. |
© 2021 by the authors. Licensee MDPI, Basel, Switzerland. This article is an open access article distributed under the terms and conditions of the Creative Commons Attribution (CC BY) license (https://creativecommons.org/licenses/by/4.0/).